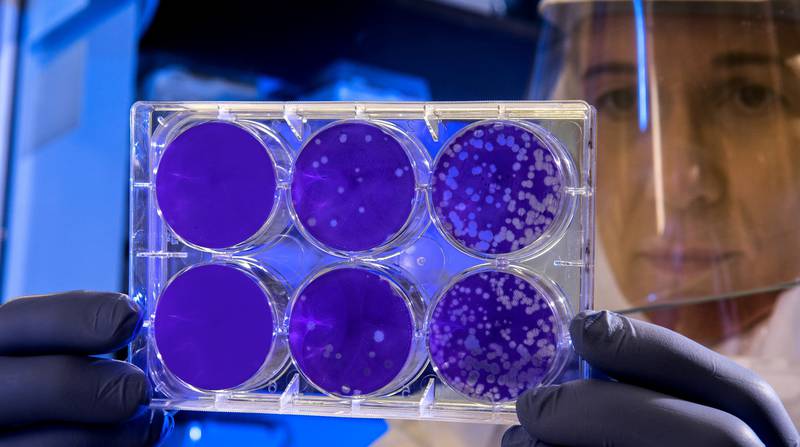

Научные организации могут получить право вести образовательную деятельность по программам специалитета
Соответствующий законопроект принят Госдумой в первом чтении.
Научные организации могут получить право вести образовательную деятельность по программам специалитета. Соответствующий законопроект Государственная Дума приняла в первом чтении.
Документ предлагает предоставить научным организациям право осуществлять образовательную деятельность по программам специалитета. Перечень учреждений, критерии их отбора, основания для включения и исключения организаций из этого перечня определит правительство РФ.
Авторами инициативы выступили председатель Совета Федерации Валентина Матвиенко и председатель комитета Совета Федерации по науке, образованию и культуре Лилия Гумерова. Поправки предлагается внести в закон «Об образовании».
В качестве примера авторы законопроекта в пояснительной записке к нему отметили опыт проведения эксперимента по реализации программы специалитета «Лечебное дело» на базе Национального медицинского исследовательского центра им. В. А. Алмазова. Сегодня в Центре им. Алмазова по программе специалитета обучается 769 студентов. В ходе приемной кампании 2022 года конкурс составил 57 человек на место, в сравнении с 2021 г. в два раза больше абитуриентов было зачислено без вступительных испытаний: 13 победителей и призеров олимпиад школьников. В 2023 году планируется прием еще 237 обучающихся. Впервые участвуя в рейтинге лучших вузов России RAEX-100, в 2022 году Центр занял 51 место.
«Четырехлетний опыт реализации Центром программы специалитета показывает, что проводимый эксперимент является успешным и подтверждает необходимость предоставить в целом научным организациям возможность реализации программ специалитета путем внесения соответствующих изменений в статью 31 Федерального закона "Об образовании в Российской Федерации"», — говорится в пояснительной записке.
Сейчас научные организации могут осуществлять образовательную деятельность по программам магистратуры, программам подготовки научных и научно-педагогических кадров, программам ординатуры, профессионального обучения и дополнительным профессиональным программам.
Ожидается, что «предоставляемое научным организациям право реализации программ специалитета позволит подготовить еще больше высококвалифицированных специалистов, которые необходимы в нынешних реалиях времени для технологического развития и модернизации экономики страны».
ФОТО: unsplash.com
